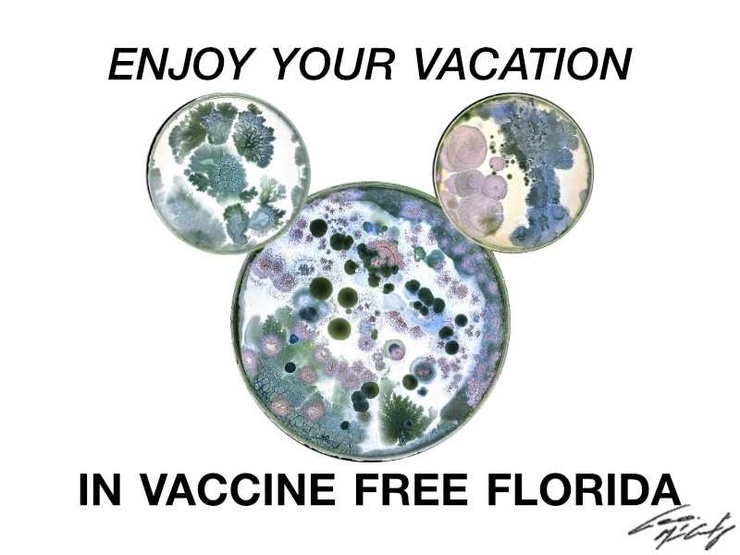

Liberal/Progressive Party
This is for proud liberal/progressive Agnostic/Atheist Democrats who love politics, humor and an informative, nice place to hang.
This is for proud liberal/progressive Agnostic/Atheist Democrats who love politics, humor and an informative, nice place to hang.
Recent Posts by members only
Liberal/Progressive Party
Sep 2025
Posted by mcgeo52

Shared from Politics
Aug 2024
Posted by Druvius




Liberal/Progressive Party
May 2024
Posted by CliffordCook

Liberal/Progressive Party
Apr 2024
Posted by CliffordCook



Liberal/Progressive Party
Jan 2024
Posted by Corvislover





Shared from Politics
Jan 2024
Posted by CliffordCook



Shared from Politics
Jan 2024
Posted by CliffordCook





Liberal/Progressive Party
Nov 2023
Posted by Corvislover




Liberal/Progressive Party
Nov 2023
Posted by Buttercup



Liberal/Progressive Party
Sep 2023
Posted by godfree2


Posts
Jun 2023
Posted by johnnyrobish





Posts
May 2023
Posted by johnnyrobish



Posts
May 2023
Posted by johnnyrobish




Posts
May 2023
Posted by johnnyrobish



Posts
May 2023
Posted by Beowulfsfriend

Liberal/Progressive Party
May 2023
Posted by CliffordCook





Liberal/Progressive Party
May 2023
Posted by johnnyrobish



Posts
May 2023
Posted by johnnyrobish





Liberal/Progressive Party
May 2023
Posted by johnnyrobish



Liberal/Progressive Party
Apr 2023
Posted by johnnyrobish




Liberal/Progressive Party
Apr 2023
Posted by LaDizdeOdd

Liberal/Progressive Party
Apr 2023
Posted by LaDizdeOdd




Posts
Apr 2023
Posted by johnnyrobish



Liberal/Progressive Party
Apr 2023
Posted by johnnyrobish





Liberal/Progressive Party
Apr 2023
Posted by LaDizdeOdd





Note: you must be a member to view more groups or posts.
Photos 791 More
Posted by DruviusTrump sinks to a new low.
Posted by CliffordCookIf you're going to punch, punch up, don't punch down. [app.suno.ai]
Posted by CorvisloverI drive a naked car since I live in a dark red state...
Posted by CliffordCook What Counts As A Trump Faith Leader In Iowa For The 2024 Caucuses There are 99 counties in Iowa, and Donald Trump would like to claim that he has support from a religious leader from every one of ...
Posted by CliffordCook Donald Trump's Political Ally in Iowa Believes She Is Fighting Evil Sorcerers of Baal and Promises Genocide To get a sense of how dangerously unhinged the Republican Party has become, let's look ...
Posted by CorvisloverBorrowed from my cousin.
Posted by ButtercupClever turn
Posted by johnnyrobishDeSantis Borrows a Page from Hitler - Vows to ‘Destroy Leftists’ When Elected So, it seems Donald Trump isn't the only Republican candidate for president who spent Memorial Day vowing to crush ...
Posted by johnnyrobishFascist Oath Keepers’ Leader Stewart Rhodes Gets 18 Years for ‘Seditious Conspiracy’ Oath Keepers founder Stewart Rhodes was sentenced to 18 years in prison Thursday in the first punishment ...
Posted by johnnyrobishLauren Boebert Claims She Quit Taking Birth Control Because It's Cheaper to Have a Kid At a recent House Oversight hearing on drug prices, Boebert told a personal story about her access to ...
Posted by johnnyrobishRepublicans Moving on From Book Banning to Jailing Librarians The Washington Post reports that while Republicans claim they only want to keep “harmful” material away from children, new state ...
Posted by CliffordCook Beware The Satanic Mermaids A pro-Trump Christian Nationalist rally down, endorsed by Donald Trump, on Trump's property in Doral, Florida featured Amanda Grace, a Christian prophet who declared ...
Posted by johnnyrobishNew Florida Law Allows Providers To Deny People Healthcare Based On ‘Moral Objections’ Florida Gov.
Posted by johnnyrobishTexas Republican Angry that Folks Want More than ‘Thoughts and Prayers’ The Washington Post reports that investigators say the gunman who opened fire on an outlet mall in a Dallas suburb on ...
Posted by johnnyrobishMarjorie Taylor Greene Wants to Ban Adult Websites Like Pornhub The Daily Beast reports that Marjorie Taylor Greene is disgusted that websites like “Pornhub” exist and even more “horrified”...
Posted by johnnyrobishNewsmax Wants Tucker Carlson to Run Their Entire Network TMZ is reporting that right-wing cable news channel Newsmax is working hard to land former Fox News anchor and White Nationalist Tucker ...

